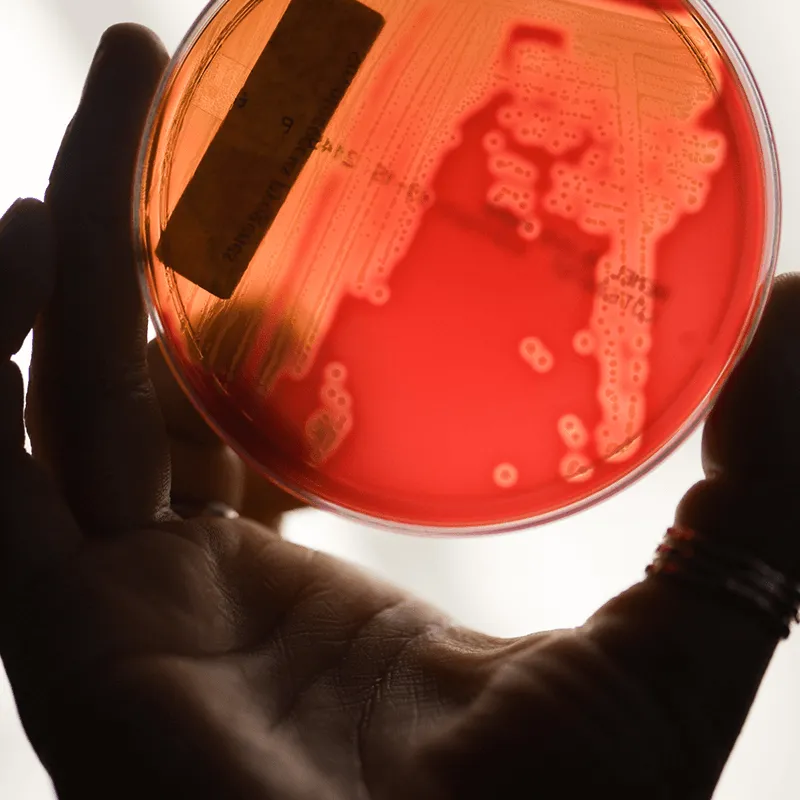

UVM Health Network sites include the FitzPatrick Cancer Treatment Center at Champlain Valley Physician’s Hospital, the National Life Cancer Treatment Center at Central Vermont Medical Center, the Reddy Cancer Treatment Center at Alice Hyde Medical Center, Elizabethtown Community Hospital, Porter Medical Center, and the UVM Medical Center, the UVM Health Network's academic medical center.
The UVM Cancer Center also works more broadly across the community and works in collaboration with community organizations and clinical sites outside the UVM Health Network to facilitate referral care, clinical research, cancer prevention, screening and community education.

Patient Resources
Visit Cancer Care at The University of Vermont Medical Center for more information about clinical services and cancer care. Here you'll find:
Support groups directory New patient guide (PDF) Resources for patients Cancer rehabilitation: Steps to Wellness exercise class Genetic testing for cancer Integrative oncology (massage, yoga, acupuncture, reiki, and more) Patient Newsletter Sign-Up Form
Clinical Trials
Clinical trials are often the best option for patients with cancer. It's an opportunity to receive a therapy that is potentially more effective and less toxic along with the standard of care.
Find a Clinical Trial Clinical Trials Office Frequently Asked Questions
Community Resources
Across Vermont and Northern New York, community organizations are serving cancer patients, cancer caregivers, and families.
Vermonter State Cancer Coalition New York State Cancer Coalition
Patient E-Newsletter
This e-newsletter is informed by a team of oncologists, patients, and supportive services providers. It is sent three times per year (fall, winter, and spring).
View the Latest Issue Sign Up to Receive the NewsletterClinical News

UVM Cancer Center Hosts 2nd Annual Rural Health and Cancer Conference
Today’s Clinical Trials Are Tomorrow’s Standard of Care
UVM Cancer Center Welcomes 90 High School Students for Careers in Cancer Program
UVM Cancer Center Publishes 2025 Annual Report
UVM Cancer Center Hosts Third Annual Scientific Retreat
UVM Cancer Center’s Rural Cancer Care Initiatives
Patient Newsletter Sign Up Form
The patient newsletter is mailed three times per year (fall, winter, and spring).
